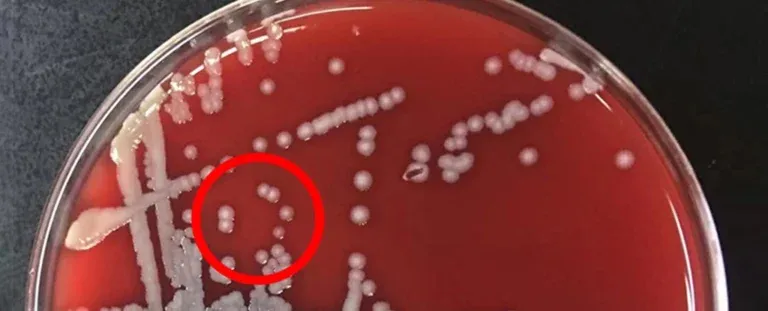
Вчені виявили фермент, який провокує депресію

Дивне прискорення таємничого міжзоряного гостя нарешті пояснено
Таємниця дивного прискорення Оумуамуа, міжзоряного гостя, який пройшов через нашу Сонячну систему у 2017 році, нарешті розгадана. Згідно з новим…

Таємниця дивного прискорення Оумуамуа, міжзоряного гостя, який пройшов через нашу Сонячну систему у 2017 році, нарешті розгадана. Згідно з новим…

Видання Whatcar.com спільно зі страховою компанією MotorEasy склало невеликий рейтинг надійних та ненадійних мінівенів. Для цього фахівці провели опитування серед…

Військово-повітряні сили Сполучених Штатів запросили фінансування для модернізації ядерного бомбардувальника B-21 Raider. Запит включено в обґрунтування бюджету досліджень і розробок…

Паркування авто на схилі без «ручника» може призвести до поломки АКПП. Припаркувавшись на крутому схилі, автомобіль з автоматичною трансмісією потрібно…

Останній звіт Міжурядової групи експертів ООН зі зміни клімату (МГЕЗК) містить тривожне попередження про нинішній стан планети. Звіт, який є…

Наразі це стосується порталів марок Porsche і Seat. Скоріш за все, що закрити доступ міг як сам концерн Volkswagen Group,…

Віддалений райський острів у Тихому океані став місцем жахливого явища: пластикових скель. Острів Хендерсон, розташований на півдорозі між Новою Зеландією…

Сили оборони України вже майже рік використовують американські дрони-камікадзе Switchblade 300. Однак відео з цими боєприпасами все ще є рідкістю.…

Щодня представники патрульної поліції зупиняють десятки автомобілів за різноманітні порушення. Якщо ряд водіїв допускає дріб’язкові порушення правил дорожнього руху, інші…
Депресія – це поширений психічний розлад, від якого страждають мільйони людей у всьому світі, з різними причинами та факторами, що…